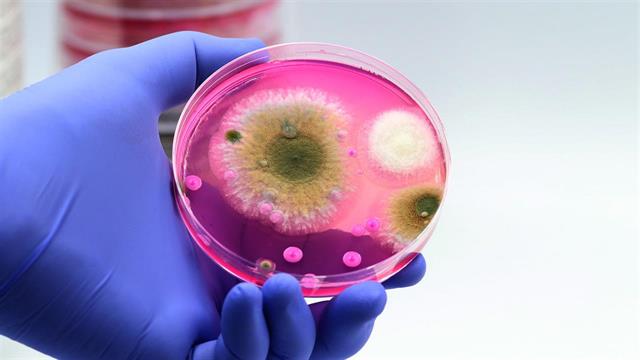
Αντιμυκητιασικά σε καρκινοπαθείς: H φαρμακευτική παρακολούθηση αποφεύγει την υποδοσολογία

Οι διεισδυτικές μυκητιασικές λοιμώξεις θέτουν σε κίνδυνο τη ζωή πολλών καρκινοπαθών, αλλά τα αντιμυκητιασικά που χρησιμοποιούνται συχνά υποδοσολογούνται. Αυτό δείχνουν τα πρώτα αποτελέσματα μιας μελέτης που παρουσιάστηκε στο ετήσιο συνέδριο της Γερμανικής Εταιρείας Αιματολογίας και Ιατρικής Ογκολογίας στο Αμβούργο.
Οι καρκινοπαθείς μπορεί να υποφέρουν από διεισδυτικές μυκητιασικές νόσους ως αποτέλεσμα της νόσου τους, για παράδειγμα στις λευχαιμίες. Ακόμη συχνότερα, οι μυκητιάσεις είναι συνέπεια της σχετιζόμενης με τη θεραπεία ανοσοκαταστολής.
Η θεραπεία γίνεται συνήθως με αζόλες, των οποίων η φαρμακοκινητική είναι δύσκολο να προβλεφθεί. Η μελέτη MAAMY διερευνά επί του παρόντος σε τρία εκπαιδευτικά νοσοκομεία της Γερμανίας κατά πόσον η παρακολούθηση των θεραπευτικών φαρμάκων μπορεί να βελτιώσει τα αποτελέσματα.
Σε μια πρώτη φάση, οι συγκεντρώσεις φαρμάκων 222 ασθενών που εξακολουθούσαν να υποβάλλονται σε θεραπεία με ποζακοναζόλη, βορικοναζόλη ή ισοβουκοναζόλη χωρίς φαρμακευτική παρακολούθηση εξετάστηκαν μεταξύ Απριλίου 2021 και Μαρτίου 2022.
Παρόλο που οι δοσολογίες ήταν σύμφωνες με τις συστάσεις των εξειδικευμένων εταιρειών, συχνά δεν επιτυγχάνονταν οι απαραίτητες θεραπευτικές συγκεντρώσεις. Αυτό συνέβαινε ιδιαίτερα συχνά με τη βορικοναζόλη: σύμφωνα με τον Till Klein από το Πανεπιστημιακό Νοσοκομείο του Μονάχου, μόνο 11 από τους 14 ασθενείς (78,6 %) πέτυχαν τα απαιτούμενα επίπεδα φαρμάκου.
Μια πιθανή αιτία είναι οι γενετικές διαφορές στον μεταβολισμό της βορικοναζόλης στο ήπαρ, ο οποίος λαμβάνει χώρα εκεί μέσω του ενζύμου κυτόχρωμα P450 2C19 (CYP2C19). Η δραστικότητα μπορεί να διαφέρει σημαντικά από άτομο σε άτομο για γενετικούς λόγους. Στους λεγόμενους "ταχείς μεταβολιστές", η αποσύνθεση της βορικοναζόλης είναι αυξημένη, γεγονός που οδηγεί σε χαμηλότερα επίπεδα δραστικής ουσίας. Η ταυτόχρονη λήψη άλλων φαρμάκων μπορεί να έχει το ίδιο αποτέλεσμα εάν αυξάνουν τη δραστηριότητα του CYP2C19.
Επίσης, στη δεύτερη φάση της μελέτης, η οποία περιελάμβανε θεραπευτική φαρμακευτική παρακολούθηση με εργαστηριακούς ελέγχους, συχνά δεν επιτεύχθηκαν αρχικά θεραπευτικά επίπεδα φαρμάκου. Αυτό συνέβη σε 12 από τους 36 ασθενείς (33,3%) μετά τη θεραπεία με ποζακοναζόλη, σε 10 από τους 13 ασθενείς (76,9%) μετά τη θεραπεία με βορικοναζόλη και σε 15 από τους 28 ασθενείς (53,6%) μετά τη θεραπεία με ισαβουκοναζόλη.
Στην ομάδα της φορικοναζόλης είχε προσδιοριστεί ο φαινότυπος CYP2C19: Από τους δέκα ασθενείς με ανεπαρκείς συγκεντρώσεις φαρμάκου, τέσσερις δεν είχαν κανέναν από τους πολυμορφισμούς CYP2C19 που εξετάστηκαν και τρεις ήταν ταχείς μεταβολιστές. Συνεπώς, ο φαινότυπος CYP2C19 από μόνος του δεν μπορεί να εξηγήσει την υποδοσολογία.
Σύμφωνα με τον Klein, ένας πιθανός συγχυτικός παράγοντας θα μπορούσε να είναι η ταυτόχρονη λήψη μεταμιζόλης. Ο "επαγωγέας" του CYP2C19 μπορεί να μείωσε τις συγκεντρώσεις του φαρμάκου σε πέντε ασθενείς που έλαβαν θεραπεία με βορικοναζόλη ή ισοβουκοναζόλη. Σε αυτές τις ομάδες, 26 προσαρμογές της δόσης και 10 αλλαγές του φαρμάκου συστήθηκαν στο 80,8% και στο 100% των ασθενών, αντίστοιχα, σύμφωνα με τον Klein.
Η μελέτη δείχνει ότι η υποδοσολογία των αντιμυκητιασικών από την ομάδα των αζολών είναι συχνή στους καρκινοπαθείς και θα μπορούσε να θέσει σε κίνδυνο την επιτυχία της θεραπείας. Ο φαινότυπος του CYP2C19 δεν μπορεί να το εξηγήσει αυτό σε κάθε περίπτωση και, σύμφωνα με τον Klein, οι ογκολόγοι θα ήταν καλό να προσδιορίσουν τη συγκέντρωση του φαρμάκου και ενδεχομένως να προσαρμόσουν τη δόση.
Ειδήσεις υγείας σήμερα
''Παπάγεια 2026'' στο Ίδρυμα ''Θεοτόκος''
Rethink Drink 360°: Ένα νέο πρότυπο συνεργασίας για την υπεύθυνη κατανάλωση αλκοόλ ξεκινά από τη Λάρισα
Φοιτητές στην Πράξη" - Συνεργασία με το Γεωπονικό Πανεπιστήμιο Αθηνών Εισερχόμενα
Η Ελλάδα πρώτη σε θανάτους από καρκίνο στην ΕΕ και δεύτερη στον ΟΟΣΑ [πίνακας]
Η Ελλάδα πρώτη σε θανάτους από καρκίνο στην ΕΕ και δεύτερη στον ΟΟΣΑ [πίνακας] Ozempic και Mounjaro: Ενδείξεις ότι "φρενάρουν" τον καρκίνο
Ozempic και Mounjaro: Ενδείξεις ότι "φρενάρουν" τον καρκίνο Πάνω από 7 δισ. δολάρια η αγορά των τεστ για καρκίνο του τραχήλου - Kυριαρχεί το τεστ Παπ
Πάνω από 7 δισ. δολάρια η αγορά των τεστ για καρκίνο του τραχήλου - Kυριαρχεί το τεστ Παπ Βασιλακόπουλος: Εντυπωσιακά αποτελέσματα στην επόμενη δεκαετία για τα mRNA εμβόλια κατά του καρκίνου
Βασιλακόπουλος: Εντυπωσιακά αποτελέσματα στην επόμενη δεκαετία για τα mRNA εμβόλια κατά του καρκίνου 3ο Συνέδριο Ασθενών: Ο καρκίνος του μαστού στην Ελλάδα σήμερα
3ο Συνέδριο Ασθενών: Ο καρκίνος του μαστού στην Ελλάδα σήμερα Η Agata Jakoncic στο Most Powerful Women Summit 2026
Η Agata Jakoncic στο Most Powerful Women Summit 2026 Ημικρανίες: Καιρός και ατμοσφαιρική ρύπανση αυξάνουν τις κρίσεις
Ημικρανίες: Καιρός και ατμοσφαιρική ρύπανση αυξάνουν τις κρίσεις Ατοπική δερματίτιδα και καλοκαίρι: Φίλος ή εχθρός ο ήλιος;
Ατοπική δερματίτιδα και καλοκαίρι: Φίλος ή εχθρός ο ήλιος; Η "γκρίζα ζώνη" των ΦΥΚ (1B) και το δύσκολο σταυρόλεξο για το υπουργείο Υγείας
Η "γκρίζα ζώνη" των ΦΥΚ (1B) και το δύσκολο σταυρόλεξο για το υπουργείο Υγείας Πάνω από 3 δισ. ευρώ τα "φέσια" του δημοσίου στην αγορά - Νέα άνοδος
Πάνω από 3 δισ. ευρώ τα "φέσια" του δημοσίου στην αγορά - Νέα άνοδος 'Εγκριση της ουσίας μιταπιβάτη στην Ευρωπαϊκή Ένωση για ενήλικες ασθενείς με θαλασσαιμία
'Εγκριση της ουσίας μιταπιβάτη στην Ευρωπαϊκή Ένωση για ενήλικες ασθενείς με θαλασσαιμία Προβλήματα πρόσβασης σε θεραπεία αποσιδήρωσης [infographic]
Προβλήματα πρόσβασης σε θεραπεία αποσιδήρωσης [infographic] Τι αλλάζει για νοσηλευτές-διασώστες η ένταξη στα Βαρέα και Ανθυγιεινά
Τι αλλάζει για νοσηλευτές-διασώστες η ένταξη στα Βαρέα και Ανθυγιεινά Αντιμετώπιση της παχυσαρκίας: Mια προτεραιότητα της πολιτικής για τη βιωσιμότητα του συστήματος υγείας
Αντιμετώπιση της παχυσαρκίας: Mια προτεραιότητα της πολιτικής για τη βιωσιμότητα του συστήματος υγείας Κεραμέως: Βαρέα και ανθυγιεινά για νοσηλευτές και διασώστες ΕΚΑΒ
Κεραμέως: Βαρέα και ανθυγιεινά για νοσηλευτές και διασώστες ΕΚΑΒ Άνοιξε η πόρτα για αποζημίωση των CGM σε άτομα με διαβήτη τύπου 2 που λαμβάνουν ινσουλίνη
Άνοιξε η πόρτα για αποζημίωση των CGM σε άτομα με διαβήτη τύπου 2 που λαμβάνουν ινσουλίνη Απώλεια μυϊκής μάζας με τους αγωνιστές GLP-1 ανησυχεί τους ειδικούς
Απώλεια μυϊκής μάζας με τους αγωνιστές GLP-1 ανησυχεί τους ειδικούς